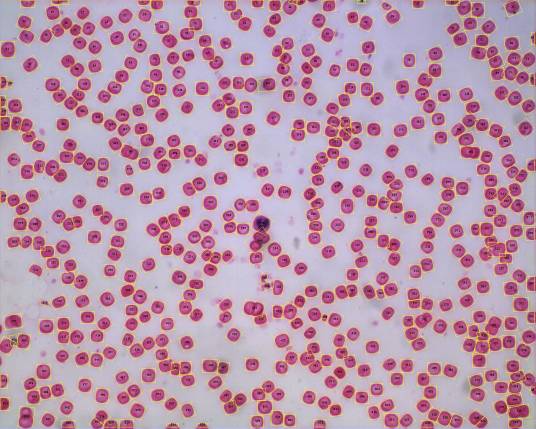

-
红细胞计数 编辑
红细胞(RBC)是人体中最多的一类细胞。它的主要生理功能是通过细胞内所含有的血红蛋白进行氧与二氧化碳的交换。红细胞的寿命约为120天,每天都有许多红细胞因衰老而死亡,另外又有许多新生的红细胞取代衰老的红细胞,使红细胞数量保持着动态平衡,以保持身体新陈代谢的正常需要。有多种原因可造成红细胞生成和破坏的平衡失调,结果一方面使红细胞数量减少或增多,从而引起贫血或红细胞增多症;另一方面使红细胞在质量上发生改变。通过对红细胞数量和形态学及生化改变的检查,对鉴别和诊断某些疾病具有重要的临床意义。
1.生理性增加
见于新生儿、高原居民等。
2.病理性增加
见于真性红细胞增多症、各种原因导致的脱水、先天性心脏病、肺心病等。
3.减少
见于各种贫血(如再生障碍性贫血、缺铁性贫血、铁粒幼细胞性贫血、巨幼细胞性贫血、溶血性贫血、地中海性贫血等)、大量失血(如外伤大出血、手术大出血、产后大出血、急性消化道出血、溃疡所致的慢性失血等)、白血病、产后、化疗等。
红细胞数与血红蛋白之间有一定比例关系,在某些贫血患者,两者之间的比例关系有变化,同时观察分析两个结果,对贫血的诊断和鉴别有一定意义。
1.男性
(4.5~5.5)×1012/L(450~550万/mm3)
2.女性
(4.0~5.0)×1012/L(400~500万/mm3)
3.婴儿
(6.0~7.0)×1012/L(600~700万/mm3)
4.儿童
(4.2~5.2)×1012/L(420~520万/mm3)
1、本站所有文本、信息、视频文件等,仅代表本站观点或作者本人观点,请网友谨慎参考使用。
2、本站信息均为作者提供和网友推荐收集整理而来,仅供学习和研究使用。
3、对任何由于使用本站内容而引起的诉讼、纠纷,本站不承担任何责任。
4、如有侵犯你版权的,请来信(邮箱:baike52199@gmail.com)指出,核实后,本站将立即删除。